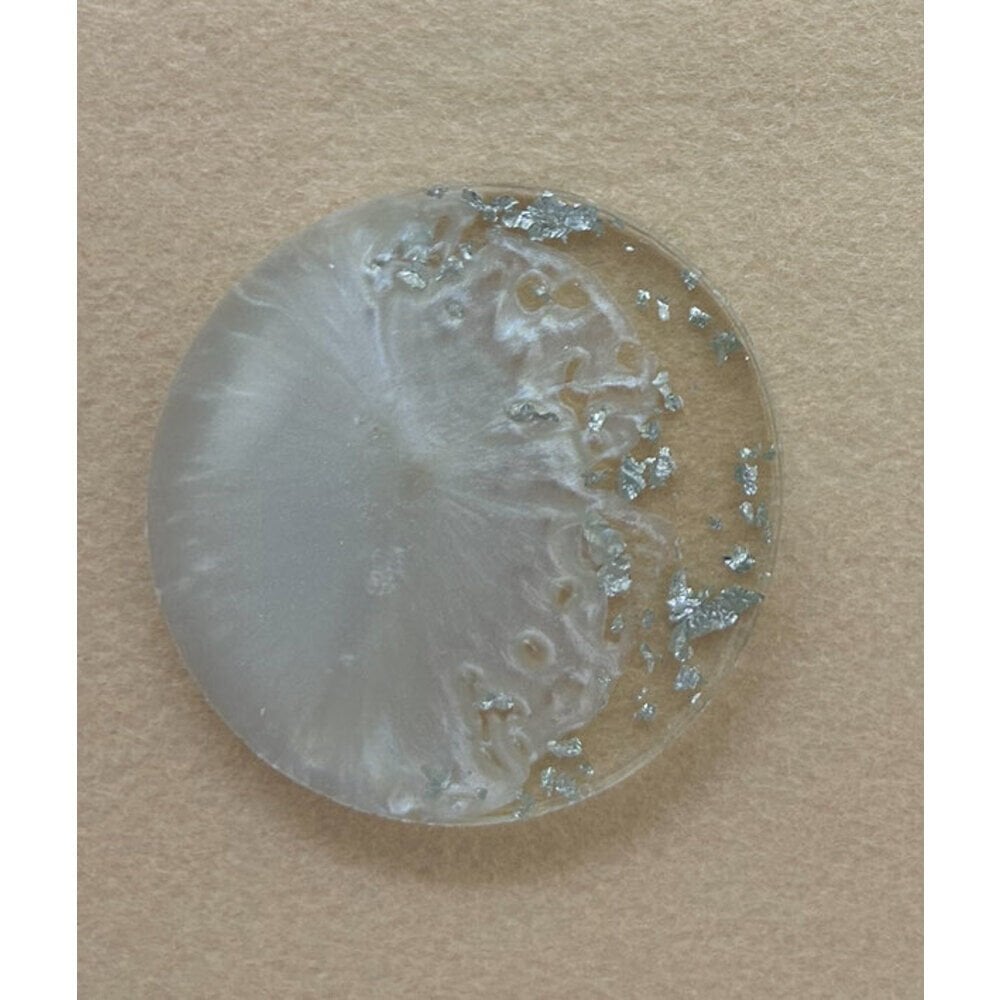
Yuvarlak Sedef Gümüş Epoksi Magnet 100 Adet

Yuvarlak Sedef Gümüş Epoksi Magnet 100 Adet
550,00 TL
Kategori
Kargo
Kargo Ücreti Alıcı Tarafından Kapıda Ödenir
Yuvarlak Sedef Gümüş Epoksi Magnet 100 Adet
Yuvarlak Sedef gümüş simli
6,5cm Çapında 4 Milim Kalınlığındadır.
Etiket ölçüsü 4*3cm Ovaldir.
Ürünlerin Arkasında Mıknatıs Yoktur.
Düğün, nişan, kına, sünnet düğünü veya doğum günlerinde misafirlerine uygun şekilde düzenleyip paketleyip hoş bir hediye olarak dağıtılabilir
Yuvarlak Sedef gümüş simli
6,5cm Çapında 4 Milim Kalınlığındadır.
Etiket ölçüsü 4*3cm Ovaldir.
Ürünlerin Arkasında Mıknatıs Yoktur.
Düğün, nişan, kına, sünnet düğünü veya doğum günlerinde misafirlerine uygun şekilde düzenleyip paketleyip hoş bir hediye olarak dağıtılabilir
Bu ürüne ilk yorumu siz yapın!
Ürün hakkında henüz soru sorulmamış.
Sitemize ilk yorumu siz yapın!

